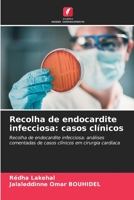
Recolha de endocardite infecciosa: casos clínicos 620561619X Book Cover

Myxoma collection: clinical cases
Out of Stock

Colecção Myxoma: casos clínicos: Colecção de mixoma, casos clínicos de cirurgia cardíaca
Out of Stock

Raccolta di mixomi: casi clinici
Out of Stock

Myxom-Sammlung: Klinische Fälle
Out of Stock

Infective endocarditis collection: clinical cases
Out of Stock
Recolha de endocardite infecciosa: casos clínicos
Out of Stock

Sammlung Infektiöse Endokarditis: Klinische Fälle
Out of Stock

Raccolta di endocarditi infettive: casi clinici
Out of Stock

Quistos hidatidos card?acos: casos cl?nicos
Out of Stock

Cardiac hydatid cysts: clinical cases
Out of Stock

Les malformations cardiaques congénitales: cas cliniques: Les malformations cardiaques congénitales
Out of Stock

VADEMEMECUM CLINIQUE: Pharmacologie des produits de contraste iodés en salle de coronarographie
Out of Stock

Difetti cardiaci congeniti: casi clinici: Difetti cardiaci congeniti
Out of Stock

Congenital heart defects: clinical cases: Congenital heart defects
Out of Stock

Angeborene Herzfehler: Klinische Fälle: Angeborene Herzfehler
Out of Stock

Pathologien der Aorta: Klinische Fälle
Out of Stock

Patologie dell'aorta: casi clinici
Out of Stock

Trauma vascolare: casi clinici: Lesioni vascolari
Out of Stock

Cardiopatias congénitas: casos clínicos: Defeitos cardíacos congénitos
Out of Stock

Kystes hydatiques cardiaques: cas cliniques
Out of Stock

Traumatismos vasculares: casos clínicos
Out of Stock

Vascular trauma: clinical cases
$44.58

Gefäßverletzungen: Klinische Fälle
Out of Stock

Patologias da aorta: casos clínicos
Out of Stock

Pathologies of the aorta: clinical cases
Out of Stock

Operacja na otwartym sercu w przypadku mas serca
Out of Stock

Chirurgie am offenen Herzen bei Herzmassen
Out of Stock

Intervento a cuore aperto per masse cardiache
Out of Stock

Open-heart surgery for cardiac masses
$50.02

Cirurgia de coração aberto para massas cardíacas
Out of Stock